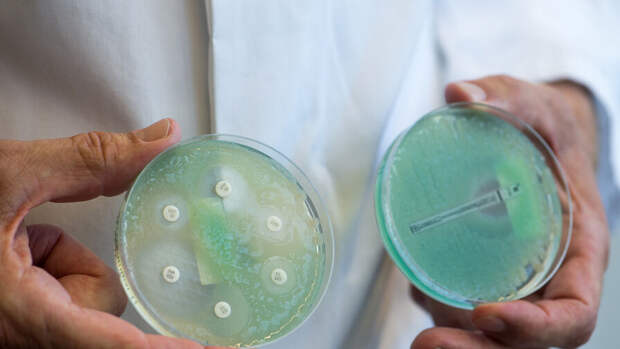

Биологи открыли новое токсичное для бактерий вещество, выделяемое синегнойной палочкой. Статья об этом опубликована в Molecular Cell.
Синегнойная палочка - это аэробные подвижные бактерии, живущие в воде и почве и вызывающие заболевания легких. Их характерной особенностью является способность окрашивать среду в сине-зеленый цвет.
Теперь ученые из Университета Макмастера выяснили, что синегнойная палочка выделяет токсин, который способен убивать другие виды бактерий. Такая реакция достигается за счет атаки на функциональные РНК, что нарушает полноценный ход жизненно необходимых процессов патогена и не дают ему размножаться. Токсин проникает в бактерию захватывает молекулу РНК.
Авторы считают, что на основе этого вещества в будущем можно будет создать семейство антибиотиков, которые действуют на живучие бактерии.
Ранее врачи показали, что прием высоких доз фолиевой кислоты повышает риск смерти от COVID в 2,6 раза.
Свежие комментарии